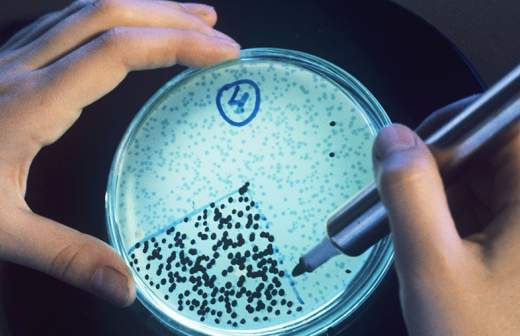

Лекарство от рака не повредит здоровые клетки

Российские ученые создали полимерные микроконтейнеры, которые разлагаются при попадании в раковые клетки и высвобождают лекарство. В здоровых клетках они остаются целыми. Такие капсулы предполагается вводить в организм в составе инъекционных растворов. Новые микроносители обеспечивают высокую эффективность лечения онкозаболеваний, минимизируя неблагоприятные побочные эффекты.
Химики из научного центра при Томском политехническом университете и медики из Института детской онкологии, гематологии и трансплантологии разработали микроконтейнеры для доставки лекарства в больные клетки. Они состоят из органической полимерной основы и неорганических наночастиц. Такие капсулы биодеградируют после поглощения раковыми клетками, что приводит к высвобождению лекарства.
Доклинические испытания на лабораторных животных показали, что вне опухоли этого не происходит.
— Микроконтейнеры сделаны из нетоксичных биоразлагаемых полимеров. В раковых клетках есть вещество глутатион. Микроконтейнеры разрушаются только там, где его концентрация высока. В здоровых клетках содержание глутатиона на несколько порядков ниже, так что лекарство остается в капсуле, — рассказал «Известиям» младший научный сотрудник лаборатории новых лекарственных форм томского центра Александр Тимин. — Тем самым мы снижаем токсичность препаратов.
По оценкам ученых, микроконтейнерный препарат будет стоить $150-200 за упаковку. Сегодня адресные лекарства обходятся примерно в $2 тыс. за упаковку без учета стоимости лекарства, которое требуется доставить.
— Многие компании заинтересовались нашей разработкой. Если мы представим ее как химиотерапию с использованием более низкой концентрации онкопрепаратов, то клинические испытания займут около пяти лет. Если же регистрировать полностью новую лекарственную форму, то на это уйдет лет пятнадцать, — пояснил Александр Тимин.
Заведующий лабораторией гетероциклических соединений Института органической химии РАН Михаил Краюшкин считает разработку сибирских ученых перспективной.
— Беда многих противораковых лекарств — в их непредсказуемом токсичном действии на здоровые ткани организма. Создание препаратов селективного действия, конечно, заслуживает исключительного внимания, — заявил он.
Высоко оценивет открытие и руководитель Центра персонализированной онкологии OncoTarget Первого МГМУ Марина Секачева.
— Разработка томских коллег отвечает на один из самых острых вопросов противоопухолевого лечения: как снизить токсичность лекарств. К сожалению, подавляющее большинство онкопрепаратов вызывает побочные эффекты. Это связано с повреждением наряду с опухолевыми здоровых клеток человека. Поэтому запрос на адресность очень велик. Надеюсь, что разработка быстро выйдет на стадию клинических испытаний с последующим внедрением, — сказала Марина Секачева.
Работа томских ученых на днях опубликована в научном журнале Particle & Particle Systems Characterization.